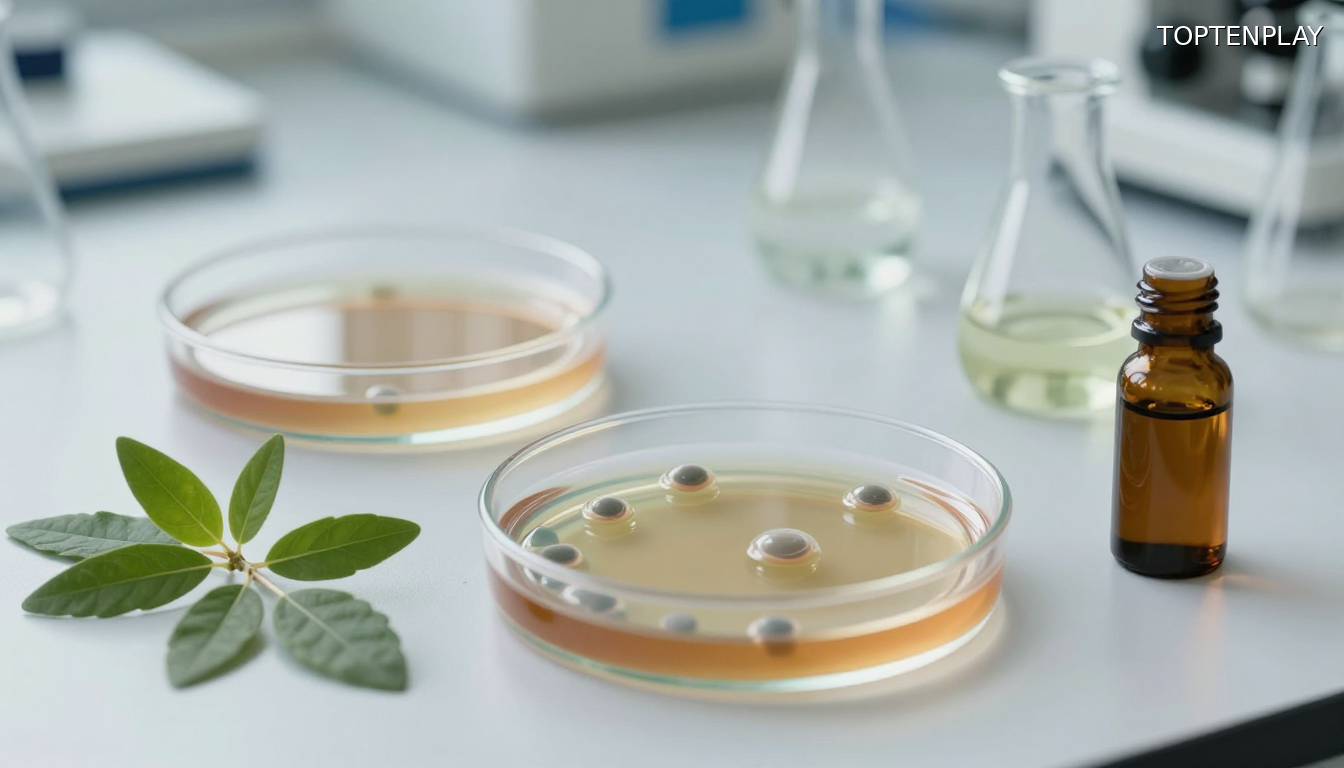
Image d'illustration © TopTenPlay EN

📌 Das Carvacrol-Compound des Oregano: Wie dieses Küchenkraut antibiotikaresistente Bakterien und chronische Entzündungen bekämpft
Posted 10 décembre 2025 by: Admin
Das Carvacrol-Compound des Oregano erweist sich als starke Waffe gegen multiresistente Bakterien und chronische Entzündungen. Laborstudien zeigen, dass das Kraut Biofilme zerstört und Entzündungsmarker um bis zu 57% reduziert, während seine antiviralen Eigenschaften 90% der Herpesvirus-Partikel inaktivieren. Trotz dieser vielversprechenden Ergebnisse sind klinische Studien am Menschen begrenzt.
Werbung:
Da wissenschaftliche Forschung zunehmend das therapeutische Potenzial des Oregano validiert, seine Fähigkeit…
Werbung:
Artikel vollständig anzeigen..
Werbung:










